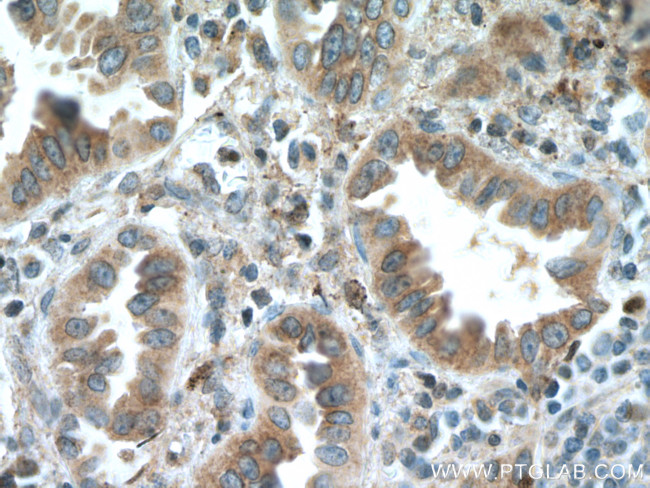
SLC25A3 Antibody in Immunohistochemistry (Paraffin) (IHC (P))

Search
Proteintech
SLC25A3 Polyclonal Antibody
{{$productOrderCtrl.translations['antibody.pdp.commerceCard.promotion.promotions']}}
{{$productOrderCtrl.translations['antibody.pdp.commerceCard.promotion.viewpromo']}}
{{$productOrderCtrl.translations['antibody.pdp.commerceCard.promotion.promocode']}}: {{promo.promoCode}} {{promo.promoTitle}} {{promo.promoDescription}}. {{$productOrderCtrl.translations['antibody.pdp.commerceCard.promotion.learnmore']}}
产品信息
10420-1-AP
种属反应
宿主/亚型
分类
类型
抗原
偶联物
形式
浓度
规格
纯化类型
保存液
内含物
保存条件
运输条件
产品详细信息
Immunogen sequence: MFSSVAHLA RANPFNTPHL QLVHDGLGDL RSSSPGPTGQ PRRPRNLAAA AVEEYSCEFG SAKYYALCGF GGVLSCGLTH TAVVPLDLVK CRMQVDPQKY KGIFNGFSVT LKEDGVRGLA KGWAPTFLGY SMQGLCKFGF YEVFKVLYSN MLGEENTYLW RTSLYLAASA SAEFFADIAL APMEAAKVRI QTQPGYANTL RDAAPKMYKE EGLKAFYKGV APLWMRQIPY TMMKFACFER TVEALYKFVV PKPRSECSKP EQLVVTFVAG YIAGVFCAIV SHPADSVVSV LNKEKGSSAS LVLKRLGFKG VWKGLFARII MIGTLTALQW FIYDSVKVYF RLPRPPPPEM PESLKKKLGL TQ (1-361 aa encoded by BC003504)
靶标信息
The protein encoded by this gene catalyzes the transport of phosphate into the mitochondrial matrix, either by proton cotransport or in exchange for hydroxyl ions. The protein contains three related segments arranged in tandem which are related to those found in other characterized members of the mitochondrial carrier family. Both the N-terminal and C-terminal regions of this protein protrude toward the cytosol.
仅用于科研。不用于诊断过程。未经明确授权不得转售。
篇参考文献 (0)
生物信息学
蛋白别名: Phosphate carrier protein, mitochondrial; Phosphate transport protein; PTP; solute carrier family 25 (mitochondrial carrier; phosphate carrier) member 3 isoform SLC25A3_1; solute carrier family 25 (mitochondrial carrier; phosphate carrier) member 3 isoform SLC25A3_2; solute carrier family 25 (mitochondrial carrier; phosphate carrier), member 3; Solute carrier family 25 member 3; unnamed protein product
基因别名: OK/SW-cl.48; PHC; PiC; PTP; SLC25A3
UniProt ID: (Human) Q00325
Entrez Gene ID: (Human) 5250